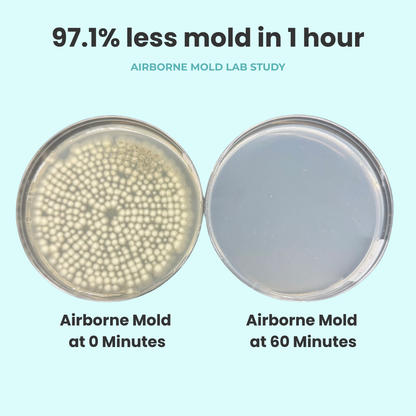
Jaspr Air Scrubber

The Detox Dudes
Jaspr Air Scrubber
Jaspr Air Scrubber
Use the code DETOXDUDES at checkout
Couldn't load pickup availability
If You Don’t Filter Your Air, Your Lungs Will.
Whisper-quiet commercial grade power with a modern, minimalist design. Jaspr shows you in real time what's in your air.
- Jaspr’s filter is over 5x larger than those in most other air purifiers.
- Filtering your air is the simplest way to improve your health.
- Filter changes are quick and easy—taking less than 30 seconds, no vacuuming required.
Indoor air is more than 5 times dirtier than outdoor air.
- Our homes are built too tight and can't breathe.
- They’re made with toxic materials and filled with furniture that off-gas VOCs.
- Our indoor air is dirty and our homes are silently making us sick.
In a recent lab test, Jaspr achieved:
- 97.1% mold removal in 1 hour
- 99.8% mold removal in 2 hours
- 100% elimination in 3 hours
Built with the highest quality materials and has a lifetime warranty.
Ingredients
Ingredients
Material: Cold Rolled Steel
Sensors: PM2.5 & VOC
Power: 73W, 1A
Rated Voltage: 100 - 120V, 60 Hz
Sound Level: 33 dBA (whisper) - 58 dBA
Filter Lifespan: 6 Months
Dimensions: 31.5 in x 11.5 in (80 cm x 29.2 cm)
Weight: 25 lbs (11.34 kg)
Carbon: 1lb
Suggested Use
Suggested Use
To create the cleanest, healthiest air throughout your home, we recommend:
✔ 1 per bedroom
✔ 1 in the living or cooking area
✔ 1 in your home office or gym
Caution: If you are pregnant or nursing, consult with your healthcare practitioner before use. Keep out of reach of children.
*These statements have not been evaluated by the Food and Drug Administration. This product is not intended to diagnose, treat, cure or prevent any disease.
View full details